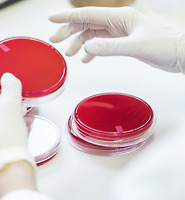

Notice
Recent Posts
Recent Comments
Link
스마트맨의원
남자 성병 잠복기 동안에도 전염될수 있다 본문
많은 분들이 증상이 없다고 나는 정상이라고 생각하며,
성병에 대해 안일하게 생각합니다.
때문에 성병에 감염되었어도 모르고 전염시키는 경우도 많습니다.
성병에 감염되었다고 해서 바로 증상이 나타나는 것은 아니며
잠복기가 있을 수 있고, 증상이 발현되는 경우도 있지만 무증상으로
나타나는 경우도 많습니다.
따라서 성병은 건강검진의 개념으로 주기적으로 검사하여
관리하는 것이 가장 이상적인 행동이며, 적어도 의샘되는 행동이
있었다면 미리미리 검사를 받으셔야 합니다.
성병잠복기는 증상이 발현될떄까지의 시간을 말하는데
성병의 원인에는 바이러스, 박테리아 원충 등이 있으며,
일반적으로 바이러스는 4주 후 검사의 정확도가 높습니다.
또한 박테리아에 의한 감염 역시 어느정도 균이 증식되어야
양성반응이 나오기 때문에 관계 후 한달 정도 뒤에 검사를
받는 것이 정확도가 높다고 하겠습니다.
일반적으로 증상이 없이 내원하여 검사를 받는 분들을 보면
새로운 이성친구를 사귄지 몇달되지 않아 상대방에게 증상이
나타나 병원을 내원하는 경우가 많습니다. 이러한 경우
본인은 증상이 없다고 하여 정상으로 보기 어렵습니다.
검사를 해보면 양성 반응이 나오는 경우가 대부분으로
증상이 없어도 수개월전에감염되어진 경우도 많습니다
이렇듯 남자 성병은 종류도 다양하며 잠복기에 따른 증상이
늦게 나타나거나 무증상으로 나타나는 경우도 많습니다.
그만큼 미리미리 관리하셔야 하며, 이러한 검사는 본인뿐만 아니라
이성친구까지 배려하는 기본적인 에티켓이라고 할 수 있겠습니다.
'성병정보' 카테고리의 다른 글
| 남성성병종류 주기적 검사가 필요하다 (0) | 2020.05.07 |
|---|---|
| 성기 사마귀, 뾰루지 원인이 멀까요 ? (0) | 2020.05.04 |
| 배뇨 시 통증과 혈뇨 요도염이 원인일수도 (1) | 2020.04.13 |
| 남자성병검사 주기적으로 받아야 하는 이유 (0) | 2020.04.07 |
| 남성 요도 통증 요도염 의심 (0) | 2020.03.26 |
Comments